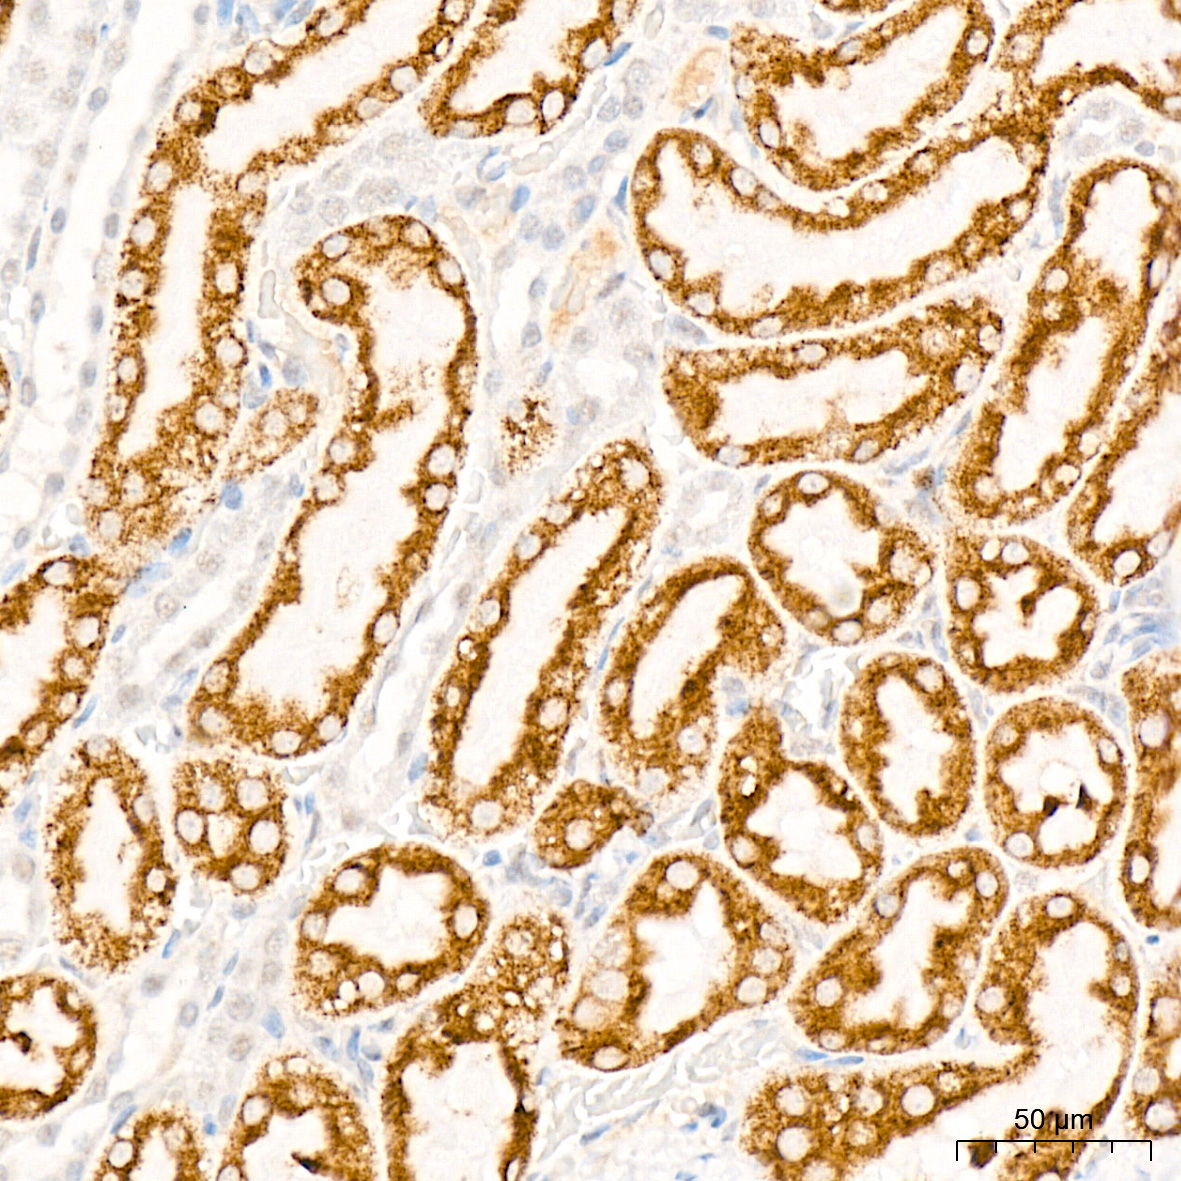
#

- Primary Antibodies
Primary Antibodies
- Unmodified/Total Antibodies(7451)
- Phospho Specific Antibodies(1920)
- Cleaved Specific Antibodies(193)
- Methyl Specific Antibodies(53)
- Acetyl Specific Antibodies(193)
- Monoclonal Antibodies(165)
- Recombinant Rabbit Monoclonal Antibodies(3614)
- RTU Mouse Monoclonal Antibodies(384)
- Mouse Monoclonal Antibodies(839)
- Secondary Antibodies
Secondary Antibodies
- Cy7 Conjugated(43)
- Cy5.5 Conjugated(43)
- Cy5 Conjugated(43)
- Cy3 Conjugated(43)
- Texas Red Conjugated(43)
- TRITC Conjugated(43)
- AMCA Conjugated(43)
- FITC Conjugated(97)
- Biotin Conjugated(93)
- HRP Conjugated(97)
- AU Conjugated(61)
- Not Conjugated(67)
- Ablight 350 Conjugated(2)
- Ablight 405 Conjugated(3)
- Ablight 488 Conjugated(4)
- Ablight 549 Conjugated(4)
- Ablight 594 Conjugated(4)
- Ablight 649 Conjugated(4)
- Ablight 680 Conjugated(2)
- Ablight 800 Conjugated(2)
- AbFluor 350 Conjugated(43)
- AbFluor 405 Conjugated(43)
- AbFluor 488 Conjugated(43)
- AbFluor 532 Conjugated(43)
- AbFluor 555 Conjugated(43)
- AbFluor 568 Conjugated(43)
- AbFluor 594 Conjugated(43)
- AbFluor 633 Conjugated(43)
- AbFluor 647 Conjugated(43)
- AbFluor 660 Conjugated(43)
- AbFluor 680 Conjugated(43)
- AbFluor 750 Conjugated(43)
- AbFluor 790 Conjugated(44)
- Molecular Biology
- ELISA Kits
ELISA Kits
- Colorimetric Cell-Based Phospho(970)
- Colorimetric Non-Phospho Cell-Based ELISA(965)
- Fluorometric Phospho Cell-Based ELISA(102)
- Colorimetric Phospho Sandwich ELISA(25)
- Chemiluminescent Sandwich ELISA(93)
- Colorimetric Non-Phospho Transcription Factor ELISA(135)
- Colorimetric Phospho Transcription Factor ELISA(73)
- Colorimetric Cell-Based Methyl(45)
- Colorimetric Cell-Based Cleaved(37)
- Colorimetric Cell-Based Acetyl(86)
- Colorimetric Sandwich ELISA(723)
- Research
Areas
Research Areas
- Cell Adhesion Proteins
- Cell Cycle Proteins
- Channel Proteins
- Exosome
- GDP/GTP Binding Proteins
- Growth Factors and Hormones
- Homeodomain Proteins
- Immunohistochemical
- Kinases and Phosphatases
- Signaling
- Membrane Receptors
- Neurobiology
- Signaling Intermediates
- Steroid Receptors
- Structural Proteins
- Synthesis and Degradation
- Transcription Regulators
- Transport and Trafficking
- Tumor Suppressors/Apoptosis
- Technical Resources
- Contact Us